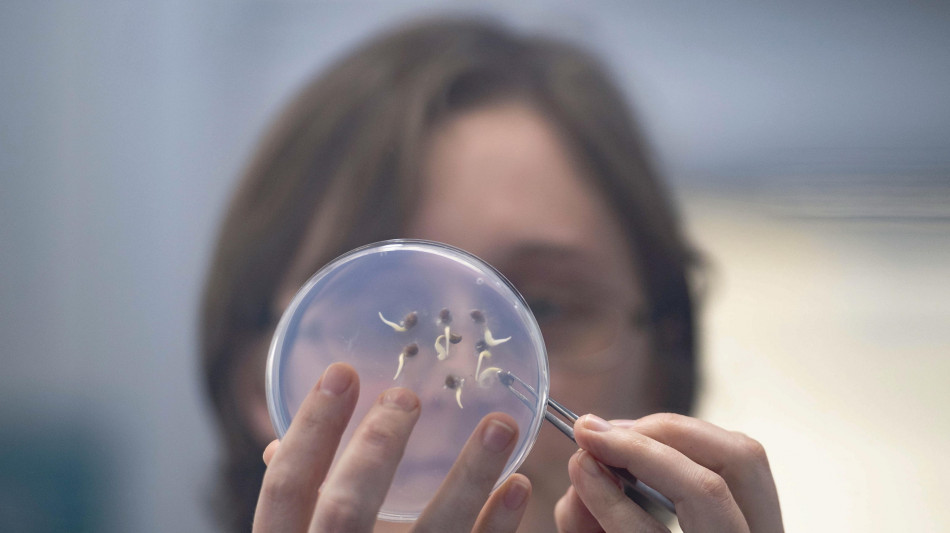
Scoperto un trucco per ingannare il metabolismo durante la dieta

Scoperto un trucco per ingannare il metabolismo durante la dieta
Nei topi, fa continuare a bruciare zuccheri anche a digiuno
È forse possibile ingannare il metabolismo in modo da continuare a perdere peso durante la dieta, grazie a un nuovo trucco scoperto da uno studio condotto sui topi: spegnendo un particolare gene, l'organismo continua a bruciare zuccheri anche quando le calorie scarseggiano, permettendo così di aggirare il rallentamento del metabolismo che spesso entra in gioco dopo la fase iniziale della dieta. La scoperta, pubblicata sulla rivista Cell Metabolism dal gruppo guidato dall'Università della Danimarca Meridionale, potrebbe portare a sviluppare un farmaco che renda più efficaci gli attuali trattamenti per la perdita di peso, ma anche quelli usati per malattie come il diabete di tipo 2. I ricercatori coordinati da Kim Ravnskjaer sono partiti dal gene Plvap, noto per avere un ruolo nel metabolismo dei grassi, che è attivo in particolare in alcune cellule del fegato. Per capirne meglio il funzionamento lo hanno disattivato, osservando ciò che succedeva nei topi: inizialmente gli animali sembravano del tutto normali, ma le cose sono cambiate completamente quando gli autori dello studio li hanno sottoposti a digiuno. Con il gene Plvap spento, il fegato non sembra riconoscere che le calorie a disposizione stanno diminuendo e quindi continua a bruciare zuccheri al posto dei grassi: questi ultimi vengono comunque rilasciati dal tessuto adiposo ed entrano in circolo, ma invece di essere assorbiti dal fegato sono reindirizzati al tessuto muscolare. I ricercatori hanno quindi scoperto una via completamente nuova per la regolazione del metabolismo del fegato. "Se riuscissimo a controllare il consumo di zuccheri e grassi da parte del fegato, potremmo anche aumentare l'efficacia dei farmaci per la perdita di peso e per il diabete", commenta Ravnskjaer. "Dagli esperimenti su topi all'immissione di un farmaco sul mercato la strada è molto lunga - aggiunge - ma questo è il potenziale della nostra ricerca".
K.Williams--BD



